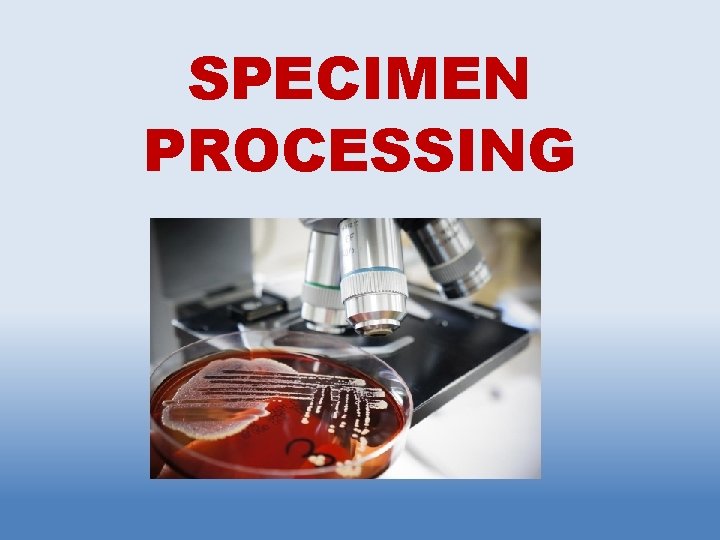
SPECIMEN PROCESSING
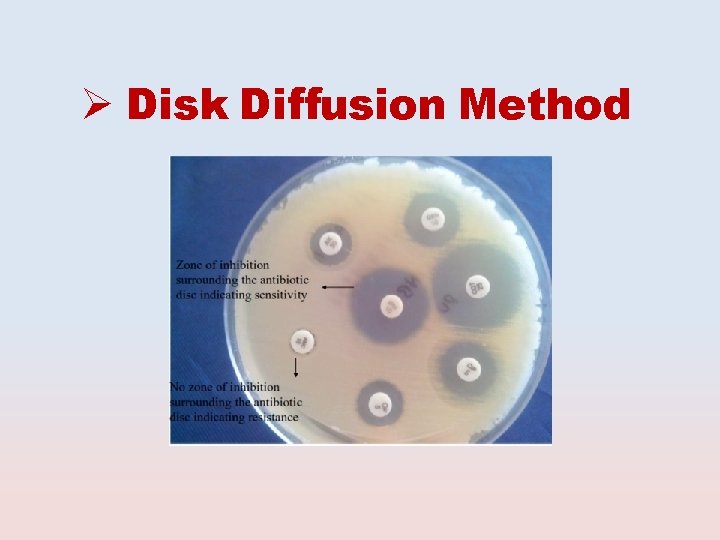
Disk Diffusion Method
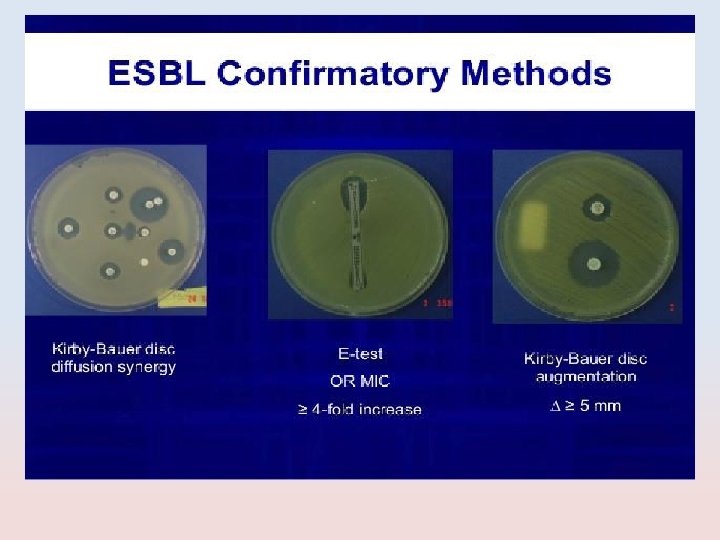
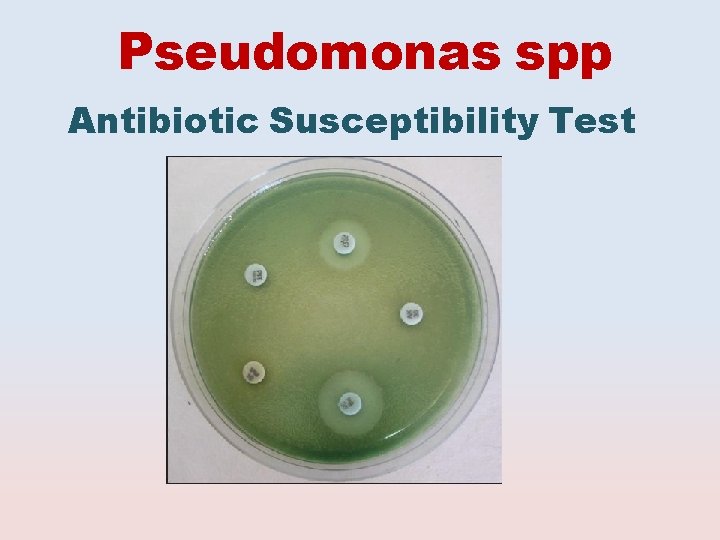
Pseudomonas spp Antibiotic Susceptibility Test
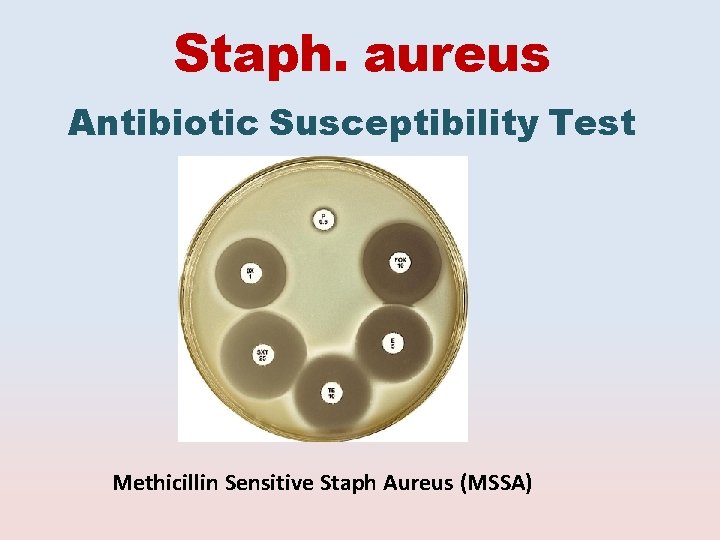
Staph. aureus Antibiotic Susceptibility Test Methicillin Sensitive Staph Aureus (MSSA)
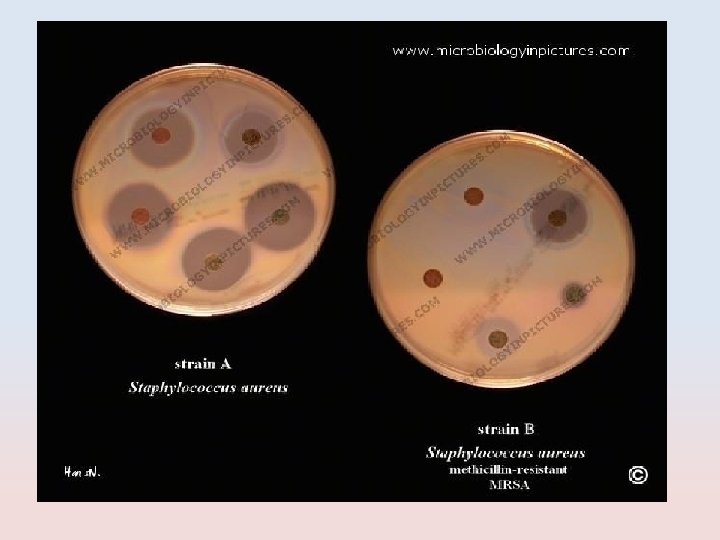
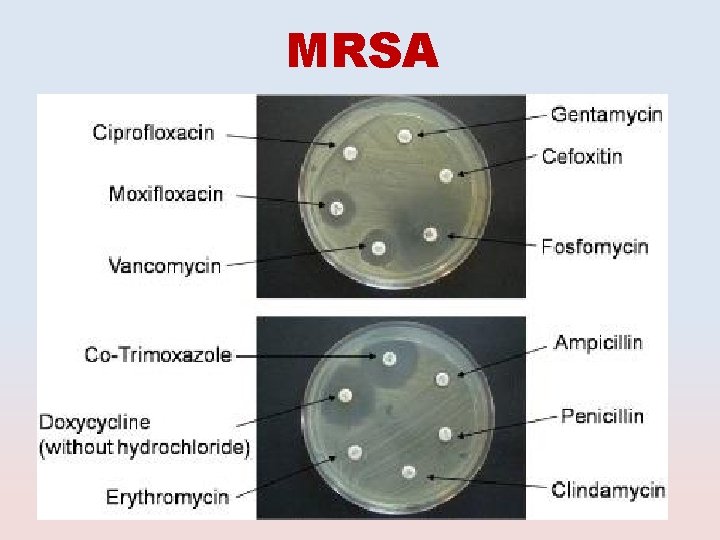
MRSA

URINARY TRACT INFECTION Microbiology Practical Class Renal System

URINARY TRACT INFECTION Microbiology Practical Class Renal System Block First Year Dr. Fawzia Al-Otaibi

Objectives It is expected that by the end of this practical class, students should be able to: 1. Know the important steps in specimen collection and transport to the lab. 2. How to process urine Specimens in the lab. – Urine microbiological and biochemical analysis. – Organisms culture and identification. – Antibiotic susceptibility testing. – Results interoperation. 3. Know the clinically important etiological Organisms associated with UTI, their identification and susceptibility testing.

SPECIMEN COLLECTION

TYPE OF SPECIMENS Midstream urine (MSU) Adhesive bag Suprapubic Aspiration Catheter sample

TYPE OF SPECIMENS Midstream. Urine(MSU) Theurinarycatheter Urinespecimensforlaboratory investigationscanbecollectedfrom catheterizedpatientsasshown (left). Thesecondportisforputting fluidsintothebladder(right). Urinefromthedrainagebagshould notbetestedbecauseitmayhave beenstandingforseveralhours. Cathetersample Adhesivebag Suprapubic. Aspiration

Sterile Urine Container Dip slides One side is CLED media, the other can be Mac. Conkey (MAC) agar or blood agar.
SPECIMEN PROCESSING

Specimen processing: 1. Urine analysis • Microbiological • Biochemical 2. Culture and identification (ID) 3. Antimicrobial Susceptibility testing 4. Results interpretation

1. Urine Analysis Biochemical Microbiological Macroscopic Microscopic

Biochemical Urine Examination (Dip stick) • leukocyte esterase • Nitrate test • PH • Glucose • Bilirubin • Protein

Testing for UTI Midstream clean catch with dipstick analysis Nitrite + → for gram-negative bacteria which can convert nitrate to nitrite (sensitivity 92 -100%, low specificity); false negative with bacteria that do not reduce nitrate gram-positive bacteria excess dietary Vitamin C Leukocyte esterase + → indicates presence of white blood cells, (sensitivity 75 -95%, specificity 94 -98%) – Dipstick results may be affected by medications/dyes, ie pyridium, nitrofurantoin, metronidazole, bilirubin, methylene blue, Vitamin B complex

Physical Urine Examination Macroscopic • Color • Odor • Turbidity

Microbiological Urine Examination Microscopic: • Cell-counting (WBC, RBC) • Parasite (Ovum, Trichomonas, yeast) • Casts

Microscopic Urine Examination (WET MOUNT) cell-counting(WBC, RBC) Casts Parasite

2. CULTURE AND ID

Culture and Identification Culture media Urine inoculation and reading of culture Identification of cultured organisms

Culture Media Routinely Used for Urine Culture Blood. Agar Mac. Conkey. Agar CLEDAgar Enrichedculturemedium, for culturingfastidiousorganism andobservedthehemolytic reaction(Beta, Alpha, Gama). Differentialculturemedium, showingbothlactoseandnonlactosefermentingcolonies. LFC=Pink. NLFC=Colorlessor appearsameasthemedium. Selectiveculturemedium, for detectionandisolation of. E. coliandcoliformbacteria inurine.

Urine Inoculation Quantitative (Colony counts) +1 +2 +3 +4 a urine sample is streaked on surface of Blood Agar plate and CLED agar / Mc Conkey agar with a special loop calibrated to deliver a known volume. Over night incubation Isolation of colonies, Biochemical tests, Drug susceptibility test, Over night incubation RESULT

Smi-Qantitative Culture of Urine Sample

ID of cultured organisms Biochemical tests. Type of hemolysis Serological tests

CLINICALLY IMPORTANT MICROORGANISMS CAUSING UTI

Etiological Agents of UTI Bacteria Fungi Parasites

BACTERIA Gram- negative bacilli • Enterobacteriace • Non-Enterobacteriace Gram-positive cocci Staphylococci Coagulase-positive (Staph. aureus) Coagulase negative (Staph. saprophyticus , Staph. Epidermidis) Streptococci Streptococcus (group B) Enterococci

Gram Negative Bacilli Enterobacteriacae Non-Enterobacteriacae


Enterobacteriacae • Escherichia coli • Klebseilla • Proteus • Enterobacter • Citrobacter

E. coli Microscopicappearance. Gramnegativebacilli Morphology Culture Mac. Conkeyagar showinggrowth of. Lactose fermenter Pinkcolonies LFC CLEDagar showinggrowth of. Lactose fermenter yellowcolonies LFC APE 20 Etest Indole Identification Test: Positive Reactions

Klebseilla spp Microscopicappearance. Gramnegativebacilli Morphology Culture Mac. Conkeyagar showinggrowth of. Lactose Fermenter Mucoid. Pink colonies LFC CLEDagar showinggrowth of. Lactose fermenter Mucoidyellow colonies LFC APE 20 Etest Indole Identification Test: Negative Reactions

Proteus spp Microscopicappearance. Gramnegativebacilli Morphology Culture plateshowing swarmof Bloodculture Proteus Identification Proteusis. Urease positive Ureasesplitsurea intoammonia; and alkalinizestheurine withproductionof crystals CLED[(Cystine. Lactose-Electrolyte. Deficient)-Inhibits The. Proteus Swarming APE 20 Etest

Non-Enterobacteriacae Pseudomonas spp Microscopicappearance. Gramnegativebacilli Morphology Mac. Conkeyagar Culture Non-Lactose Fermenter Mucoid. Pink colonies showinggrowthof Nutrient. Agar showinggrowth of. Pseudomonas pigmentation LFC Oxidasepositivetest Identification APE 20 Etest

Gram Positive Cocci Staphylococci Coagulase-positive (Staph. aureus) Coagulase negative (Staph. saprophyticus) Coagulase negative (Staph. epidermidis) Streptococcus (group B) Enterococci

Staph. aureus Microscopicappearance: Grampositivecocciinclusters Morphology Culture Identification Bloodcultureplate showinggrowthof goldenyellowcolonies + _ Coagulasetest=Positive Catalase 2 H 2 O 2 O 2+2 H 2 O Catalasetest=Positive Streptococcivs. Staphylococci

Staph. epidermidis Microscopicappearance: Grampositivecocciinclusters Morphology Culture Identification Bloodcultureplate showinggrowthof whitecolonies + _ Coagulasetest Negative Catalase 2 H 2 O 2 O 2+2 H 2 O Catalasetest=Positive Streptococcivs. Staphylococci RS Staph. epidermidisvs. Staph. saprophyticus Novobiocintest Sensitive

Staph. saprophyticus Microscopicappearance: Grampositivecocciinclusters Morphology Culture Identification Bloodcultureplate showinggrowthof whitecolonies + _ Coagulasetest= Negative Catalase 2 H 2 O 2 O 2+2 H 2 O Catalasetest=Negative Streptococcivs. Staphylococci RS Novobiocin. Test Resistant

Strept. agalactiae(group B) Microscopicappearance: Grampositivecocciinchains Morphology Culture Bloodcultureplateshowing growthof. Beta-haemolitic colonies CAMPtest Positive Catalase 2 H 2 O 2 O 2+2 H 2 O Catalasetest=Negative Streptococcivs. Staphylococci Identification Streptics Mixbacterialcolonywith variousgroup-specific antiseraonaslide

Enterococci Microscopicappearance: Grampositivecocciinchains Morphology Culture Identification Bloodcultureplateshowing growthof. Beta-haemolitic colonies ++- Both. Group. Dstreptococciand enterococciproduceapositive(left) bile. Esculinhydrolysistest. Catalase 2 H 2 O 2 O 2+2 H 2 O Catalasetest=Negative Streptococcivs. Staphylococci

FUNGI

Candida albicans Microscopicappearance: Grampositivecocciinchains Morphology Candidaalbicanson(SDA) Chlamydosporetest Positive Germtubetest Psitive onbloodagar Sabouraud's. Dextrose. Media Culture Identification

PARASITES CAUSING UTI Schistosoma haematobium

FUNGI CAUSING UTI Candida albicans

Schistosoma haematobium (urine; eggs 115 -170 x 45 -65 micrometers) (primates)

3. Antimicrobial Susceptibility Testing (AST)

Methods of AST Disk diffusion test E test

The Antibiotic Sensitivity Testing Method Selectwellisolatedcolonies Inoculumsuspension Applyantibiotics disks Readtheresult Spreadtheinoculum
Disk Diffusion Method

E TEST E-TEST Is a well-established method for antimicrobial resistance testing in microbiology laboratories. • Consists of a predefined gradient of antibiotic concentrations on a plastic strip • Used to determine the Minimum Inhibitory Concentration (MIC) of • • – Antibiotics – Antifungal agents – Antimycobacterial agents

Enterobacteriacae Antibiotic Susceptibility Test • First line UTI treatment: – – – Ampicillin TMP/SMX Ciprofloxacin Gentamicin Amikacin Nitrofunatoin

Bacterial Resistance to UTI Antibiotics Nitrofurantoin – E. coli <5% – Other uropathogens 15 -20% – Not active against • Proteus, • some Enterobacter • Klebsiella TMP-SMX (Bactrim) 10 -22% varies geographically Fluoroquinolones (Cipro) therapy for acute uncomplicated cystitis Ampicillin – 30% of E. coli resistant

Emerging resistant to Ampicillin and TMP/SMX Antibiotic MIC Interpretation Ampicillin ≥ 32 R Cephalexin ≤ 4 S Ciprofloxacin ≤ 4 S TMP/SMX ≥ 2 R Nitrofurantoin ≤ 16 S Gentamicin ≤ 8 S Ceftriaxone ≤ 1 S Imipenem ≤ 1 S Organism Source E coli urine


Extended spectrum β-lactamase (ESBL) producing E coli Antibiotic MIC Interpretation Ampicillin ≥ 32 R Cephalexin ≥ 46 R Ciprofloxacin ≤ 4 S TMP/SMX ≥ 2 R Nitrofurantoin ≤ 16 S Gentamicin ≤ 8 S Ceftriaxone ≥ 46 R Ceftazidime ≥ 46 R Imipenem ≤ 1 S ESBL positive E coli

Pseudomonas spp Antibiotic Susceptibility Test

Staph. aureus Antibiotic Susceptibility Test Methicillin Sensitive Staph Aureus (MSSA)

MRSA

Staph. saprophyticus Antibiotic Susceptibility Test Novobiocin Test Resistant


Results interpretation high probability of UTI requiring treatment If midstream clean catch positive for pyuria microscopic hematuria, with or without positive nitrites + UTI symptoms Presence of pyuria without bacteria on culture (sterile pyuria) rule out: – Tuberculosis – Interstitial cystitis (IC) – Chlamydia urethritis – Kidney disease (stone, glomerulonephritis)
- Slides: 60